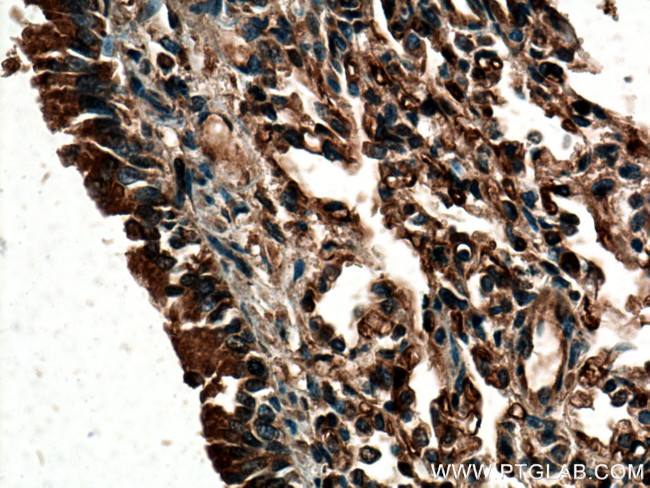
ACE Antibody in Immunohistochemistry (Paraffin) (IHC (P))

Search
Proteintech
ACE Polyclonal Antibody
{{$productOrderCtrl.translations['antibody.pdp.commerceCard.promotion.promotions']}}
{{$productOrderCtrl.translations['antibody.pdp.commerceCard.promotion.viewpromo']}}
{{$productOrderCtrl.translations['antibody.pdp.commerceCard.promotion.promocode']}}: {{promo.promoCode}} {{promo.promoTitle}} {{promo.promoDescription}}. {{$productOrderCtrl.translations['antibody.pdp.commerceCard.promotion.learnmore']}}
产品信息
24743-1-AP
种属反应
已发表种属
宿主/亚型
分类
类型
抗原
偶联物
形式
浓度
规格
纯化类型
保存液
内含物
保存条件
运输条件
产品详细信息
Immunogen sequence: FYNGKDFRI KQCTTVNLED LVVAHHEMGH IQYFMQYKDL PVALREGANP GFHEAIGDVL ALSVSTPKHL HSLNLLSSEG GSDEHDINFL MKMALDKIAF IPFSYLVDQW RWRVFDGSIT KENYNQEWWS LRLKYQGLCP PVPRTQGDFD PGAKFHIPSS VPYIRYFVSF IIQFQFHEAL CQAAGHTGPL HKCDIYQSKE AGQRLATAMK LGFSRPWPEA MQLITGQPNM SASAMLSYFK PLLDWLRTEN ELHGEKLGWP QYNWTPNSDD FYNETETKIF LQFYDQTGIW DHGAPHLLPP SQARGTREAP VYMSKRAASS GPPGSPKLPP AAQGHGEVPV HDLLWHPGPP V (390-739 aa encoded by BC036375)
靶标信息
This gene encodes an enzyme involved in catalyzing the conversion of angiotensin I into a physiologically active peptide angiotensin II. Angiotensin II is a potent vasopressor and aldosterone-stimulating peptide that controls blood pressure and fluid-electrolyte balance. This enzyme plays a key role in the renin-angiotensin system. Many studies have associated the presence or absence of a 287 bp Alu repeat element in this gene with the levels of circulating enzyme or cardiovascular pathophysiologies. Two most abundant alternatively spliced variants of this gene encode two isozymes-the somatic form and the testicular form that are equally active. Multiple additional alternatively spliced variants have been identified but their full length nature has not been determined.
仅用于科研。不用于诊断过程。未经明确授权不得转售。
生物信息学
蛋白别名: ACE; angiotensin 1 converting enzyme 1; angiotensin converting enzyme precursor (EC 3.4.15.1); angiotensin I converting enzyme (peptidyl-dipeptidase A) 1; angiotensin I converting enzyme 1; angiotensin I-converting enzyme; angiotensin I-converting enzyme (Dipeptidyl carboxypeptidase 1); angiotensin I-converting enzyme precursor (EC 3.4.15.1); Angiotensin-converting enzyme; carboxycathepsin; CD143; CD143 antigen; dipeptidyl carboxypeptidase 1; Dipeptidyl carboxypeptidase 1 (Angiotensin I-converting enzyme); Dipeptidyl carboxypeptidase I; dipeptidyl peptidase; Kininase II; MGC26566; peptidase P; unnamed protein product; Zn2+ carboxydipeptidase enzyme which transforms angiotensin I into angiotensin II an active vasoconstrictor protein; splice-site mutation IVS25+1G-->A leads to the retention of intron 25 resulting in a frameshift which leads to a premature stop codon
基因别名: ACE; ACE1; AW208573; CD143; DCP; DCP1; StsRR92
UniProt ID: (Human) P12821, (Mouse) P09470, (Rat) P47820
Entrez Gene ID: (Human) 1636, (Mouse) 11421, (Rat) 24310